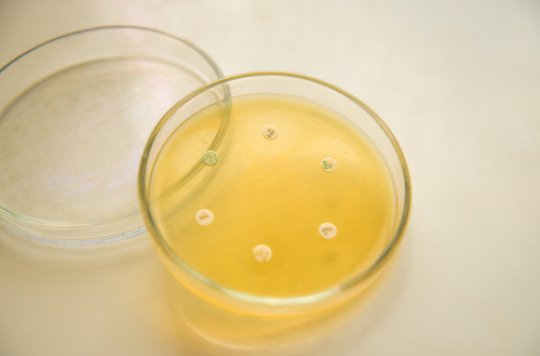
#Antibiorésistance : 10 millions de décès attendus en 2050 pourquoidocteur.fr/Articles/Quest…

StopSuperbugsEU
@stopsuperbugseu
Union Nationale des Pharmaciens Vétérinaires d'Officine - UNPVO - #antibiorésistance #superbug #antibiotics #antibiotiques #animalfarming RT not endorsement
ID: 2846500047
http://sauvonsnosantibiotiques.org 27-10-2014 10:51:20
5,5K Tweet
607 Followers
1,1K Following



.Consumers International to launch World Consumer Rights Day campaign soon to get #AntibioticsOfftheMenu bit.ly/1QqjZD0 via St. Lucia Times

Report: #McDonalds, #KFC & Subway #Antibiotics promises fall flat: ow.ly/Z6wdc #saveabx Consumers International







IBON just supported #AntibioticsOfftheMenu on Thunderclap // Consumers International thndr.me/wP8H1h

"The fight against resistance to #antibiotics must start with #animalfarming " Françoise Grossetête #AMR #superbugs The Consumer Voice europarl.europa.eu/news/en/news-r…


Food For Tomorrow 2015 - Keynote: Farming, #Antibiotics and Health Dr. Lance B. Price #antibioticresitance youtu.be/Q80TRB4tzTo





Reduced antibiotic use in #livestock wp.me/p1zQ5v-3XZ how Denmark tackled resistance via StopSuperbugsEU